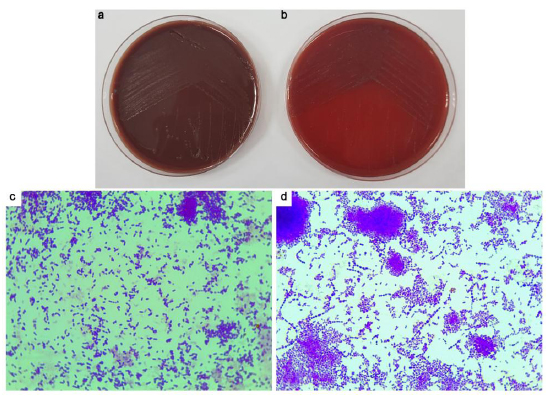

All published articles of this journal are available on ScienceDirect.
Physicochemical Properties of Torus Mandibularis and Palatinus Indicate a Source of Autogenous Bone Graft
Abstract
Introduction:
There has been extensive research on bone substitutes and autogenous bone; however, little is known about their physical and chemical characteristics of torus mandibularis and palatinus. In the present study, the physical and chemical properties of tori bone and bone graft substitutes were examined. Microbial contamination of torus bone collected during surgery was also investigated.
Objective:
To investigate the physical and chemical properties of torus mandibularis and torus palatinus, and the microbial contamination of tori bone collected during surgery.
Materials and Methods:
Torus mandibularis and palatinus were collected from healthy patients by regular surgical procedure via bone collector and a stringent aspiration protocol. Physicochemical properties such as surface structure, elemental components and the crystalline structure of tori and common bone grafting substitutes (OraGRAFT, BioOss, Cerabone) were examined via SEM-EDS, X-Ray Diffractometry analysis, and calcium dissolution assay. The bacterial morphology and gram staining from the torus samples after the surgery were analyzed.
Results:
The surface structure of tori bone differed greatly from that of bone graft substitutes. An irregular and rough surface structure was found for tori, while bone graft substitutes presented a smooth but dry pattern. Elements found within tori were similar to those within bone graft substitutes; in all cases, carbon, oxygen, sodium, magnesium, phosphate, and calcium were seen. All samples showed high crystallinity, with the highest value in Cerabone, followed by Bio-oss, torus mandibularis, torus palatinus, and Oragraft. Calcium dissolution was highest on the first day in tori samples, whereas it was constantly released until the seventh day in other bone grafts. The microbial contamination was found in all tori samples from the harvesting process, presumably due to saliva contamination.
Conclusion:
Tori bone was different from bone graft substitutes in terms of surface structure, crystallinity, and calcium release. However, tori bone and bone graft substitutes were similar in terms of elemental composition and crystal compounds, which may positively affect their clinical applications. Taken together, our findings suggest that with an effective decontamination, tori bone should be considered as a viable material for bone grafting, as it is not only practical but also cost-efficient for patients.
1. INTRODUCTION
A torus, which means to “to stand out” or “lump” in Latin [1], is an exostosis that is composed of a dense cortical and limited amount of bone marrow and is covered with a thin and poorly vascularized mucosal layer. Tori exhibit as congenital bony protuberances with benign characteristics and are caused by osteoblasts forming bony deposits along the line of fusion of the palate or on the mandible [1]. They are usually located at the longitudinal ridge of the palate, at the union of the palatine apophysis of the maxilla or at the internal side of the horizontal branch of the jaw, above the mylohyoid line, and at the level of the premolar area [1-6] and canine area [5, 7]. Additionally, tori usually exhibit a slow [1, 2] and progressive growth until an older age [1].
The precise etiology of tori remains unknown despite its long history of being investigated. The most common theory is that tori are derived from genetic variation [1, 2, 4-9]; however, researchers have not yet been able to identify any such autosomal-dominant genetic variation [6]. Another prevalent theory is that tori result from superficial injuries [1, 2] or as a sequalae from functional movements. According to Al-Bayaty et al. [4], 12.3% of the populations of Trinidad and Tobago have tori, which is comparable to a report by Bruce et al. in terms of this percentage in the population of Ghana (14.6%) [6]. In the Thai population, it has been reported that 23.1% of individuals have torus palatinus and 9.4% of individuals have torus mandibularis [3]. In addition, the majority of documented evidence has indicated that the incidence of torus palatinus is greater than that of torus mandibularis [2-5, 10, 11]. In addition, the female population appears to have a greater incidence of tori compared to that of the male population [1, 2, 11, 12]. Furthermore, there have been a few studies that have described the properties of tori itself. Most of these studies have reported that the histological organization of tori is similar to that of normal bone formation, as it is made of lamellar cortical bone with the presence of a cancellous network in the center, made of woven bone. Lacunae (Harversian canals), osteocytes, and areas with connective tissue containing dilated blood vessels have also been reported to be found in tori [2, 13].
Autogenous bone grafts are the first-line treatments for bone grafting due to several of their advantageous properties, as extensively described by numerous previous studies [14-25], which gives clinicians a better treatment prognosis and an ability to circumvent adverse immunological responses in treated patients [22, 23]. Together with autogenous bone grafts, autogenous/autologous dentin has been used in grafting purposes due to its similarity with human bone in structure and physical and chemical properties as well as its availability [24]. Nevertheless, there are still disadvantages of using autogenous grafts, such as requiring longer surgical time, donor site morbidity, and limited availability. Since harvesting of an autogenous bone graft requires an additional surgery, complications may arise such as: haemorrahage, infections, damage to adjacent structures (e.g., lingual nerve for the mandible and nasopalatine/greater palatine nerve for the palate) [1-8]. It has been well established that autogenous bone harvested as a graft material carries a potential risk of bacterial contamination from the oral microbiome, which may cause an infection leading to failure of the graft [25-27].
Bone substitutes are extensively used in various fields of dentistry, such as in oral and maxillofacial surgery, periodontics, and implantology. Specifically, bone substitutes contain organic or inorganic materials to stimulate new bone formation into bony defects [15-20, 28]. Calcium phosphate and materials that contain it, play key roles in bone induction into bony defects and to make up for bone deficiency. Furthermore, calcium phosphates show the closest similarities to the mineral components of bone [28]. One such example of calcium phosphates is calcium hydroxyapatites (HA, Ca10[PO4]6[OH]2), which act as the mineral compartment in the bone. It also comprises minimal amounts of non-collagenous proteins, including the family of bone morphogenic proteins (BMPs). Autogenous bone achieves all necessary physicochemical and biological properties desired in a bone graft material, despite there still being disadvantages due to its availability and postoperative complications at donor sites [15, 17, 19, 20, 29, 30]. Although many studies have investigated different aspects of bone substitutes and autogenous bone used in medicine and dentistry [2, 13, 31, 32], it is unknown about their physical and chemical characteristics compared with those of tori. In the present study, we investigated the physical and chemical characteristics of autogenous torus palatinus and torus mandibularis compared with those of other commonly used bone substitutes. We also investigated any bacterial contamination from the harvesting process of tori samples.
2. MATERIALS AND METHODS
2.1. Inclusion and Exclusion Criteria
All included patients were ≥18 years old, non-smokers, non-alcoholics, were medically cleared, and had torus palatinus and/or mandibularis. Patients who had any oral pathologic lesions or any bone-related diseases were excluded from the study. The protocol of this study was approved by the Faculty of Dentistry/Faculty of Pharmacy Mahidol University, Institutional Review Board is in full compliance with International Guidelines for Human Research Protection such as Declaration of Helsinki, the Belmont Report, CIOMS Guidelines and the International Conference on Harmonization in Good Clinical Practice (ICH-GCP); COE.No.MU-DT/PY-IRB 2018/061.2012
After acquiring written consent from each patient, 10 tori bone samples (five samples of torus palatinus and five samples of torus mandibularis) were collected via a bone collector during the surgical procedure from a total of nine patients. The surgical approach for the torus palatinus was with the double Y-shaped incision that was held by traction sutures and subsequent bone removal (a number of vertical cuts with a fissure bur were made and snapped off by a periosteal elevator). For the torus mandibularis, a gingival margin incision was utilized and proceeded by bone removal. A stringent aspiration protocol was performed during the surgery. One patient who had both torus palatinus and mandibularis was sampled for Scanning Electron Microscopy and Energy Dispersive X-ray Spectrometry (SEM-EDS), as well as X-ray diffraction (XRD) analysis. All 10 samples were used for calcium-phosphate dissolution analysis and assessment of microbial contamination. The demographic profiles of all patients, as well as details regarding each of their samples, are shown in Table 1.
| Sample | Age | Sex | Type of tori |
|---|---|---|---|
| 1 | 54 | F | MAN |
| 2 | 65 | M | PAL |
| 3 | 68 | M | MAN |
| 4 | 54 | F | PAL |
| 5 | 61 | F | MAN |
| 6 | 64 | F | MAN |
| 7 | 63 | F | PAL |
| 8 | 70 | F | MAN |
| 9 | 69 | M | PAL |
| 10 | 72 | M | PAL |
2.2. Bone Graft Materials
Allografts (OraGRAFT; LifeNet Health, VA, USA), xenografts (BioOss; Geistlich Pharma, Wolhausen, Switzerland), alloplasts (Cerabone; Botiss medical, Berlin, Germany), and torus particulates were used in the present study.
2.3. SEM-EDS
The surface structures of the different grafting materials were examined using a SEM-EDS (6610LV; JEOL, JSM-6610LV and Oxford, X-MaxN 50). For SEM analysis, the surface of each fresh sample was coated with a 7-nm-thick platinum (Pt) coating. Five random areas of each grafting material were investigated for their elemental analysis or chemical characterization.
2.4. Calcium Dissolution Assay
Three tubes containing 0.25 g of each grafting sample were added to 10 mL of deionized water (pH = 7.0) and incubated at 37°C. Then, 9 mL of supernatant from each tube was removed and replaced with new solution on the experimental day. The amount of calcium from each sample was measured on the first, third, fifth, and seventh days in order to investigate the level and the pattern of its release from the grafts at an early stage. The amount of calcium in the supernatant was determined by colorimetric assays using a Synergy Neo2 Hybrid multi-mode plate reader.
2.5. XRD
XRD analysis (X-Ray Diffractometer; Bruker AXS Model D8 Discover) was performed for phase identification and determination of cell dimensions via an x-ray diffractometer employing copper (Cu) radiation (λ = 1.5218 Å) over 10–60° at a rate of 1 s/step. Scherer’s equation was utilized to determine the crystallite size of the samples, as follows:
2.6. Microbial Analysis
Bacterial cultures were conducted to determine whether any bone from tori that had been surgically removed was contaminated with bacteria. After surgical removal of the tori, bone-debris samples from the bone collector were immediately dropped into a pre-weighed sterile microtube that contained 1.5 mL of Reduction Transport Fluid (RTF). The sample’s tube was then weighed again to obtain the weight of the bone sample. The samples were then transferred to a sterile test tube containing 15 mL of pre-reduced thioglycollate broth in an Airegard Laminar Airflow workstation. The samples were then incubated at 37°C in a 5% CO2 incubator and observed for turbidity of bacterial growth every 24 h. Once turbidity was evident through visual examination, bacterial detection was performed by plating onto Anaerobe Basal Agar (ABA) and Blood Agar (BA). The ABA plates were cultured under an anaerobic environment using AnaeroPack-Anaero, whereas the BA plates were cultured in ambient air at 37°C. Bacterial colony morphology and gram staining were conducted after two and five days for aerobic and anaerobic incubations, respectively.
2.7. Statistical Analysis
All data are expressed as the Mean ± Standard Deviation (SD). Social Sciences Statistical Software (SPSS, USA) was used for all statistical analysis. Calcium phosphate assays were analyzed by one-way analysis of variance (ANOVA), Tukey HSD, and Games-Howell post-hoc tests. The level for statistical significance was set at p < 0.05.
3. RESULTS
A total of 10 tori were included in the present study for microbial, physical, and chemical analyses, as shown in Table 1. These samples were retrieved from nine patients (four males and five females) with a mean age of 64 years. Sample 1 (tori mandibularis) and sample 4 (tori palatinus) were obtained from the same patient. Nevertheless, all samples were pooled and randomly selected for each experiment.

3.1. Physicochemical Properties
SEM-EDS analysis of all grafting samples revealed irregular and rough surface structures in both torus palatinus and torus mandibularis (Figs. 1 and 2). Variation in particulate sizes was also observed in both tori samples. Especially under higher magnification, irregularities and variation in surface structure were evident. We did not observe any lacunae (Harversian canals) or blood vessels in any tori samples. However, a honey-comb pattern was seen in both torus palatinus and torus mandibularis at 500× and 2000× magnification. All three commonly used bone grafts (Bio-oss, Oragraft, and Cerabone) presented with a smooth surface, while they appeared to be drier and more barren than the tori sample.

All samples in this study had similar elemental components (Table 2) that consisted of the following: Carbon (C), Oxygen (O), Sodium (Na), Magnesium (Mg), Calcium (Ca), and Phosphate (P). Chlorine (Cl) was only found in tori palatinus and tori mandibularis. The percentages of elements in each sample are shown in Table 2. Furthermore, the elemental composition of torus palatinus consisted of O, which had the highest atomic percentage, followed by C, Ca, and P; in contrast, Cl and Mg had the smallest percentages. Torus mandibularis was presented with the highest percentage of C, followed by O, Ca, and P. Interestingly, a minute amount of Aluminum (Al) was also detected in one sample of torus mandibularis. The Ca/P ratios from Bio-oss, Oragraft, and Cerabone were similar to one another (1.55 ± 0.03, 1.54 ± 0.36, and 1.41 ± 0.06), while those of torus palatinus and torus mandibularis were 1.26 ± 0.13 and 2.34 ± 1.29, respectively.
| Elements | T. palatinus | T. mandibularis | Bio-oss | Oragraft | Cerabone |
|---|---|---|---|---|---|
| C | 44.3 ± 0.72% | 46.37 ± 11.93% | 19.48 ± 3.67% | 38.62 ± 2.95% | 12.82 ± 0.44% |
| O | 47.01 ± 1.22% | 38.08 ± 13.12% | 53.77 ± 1.62% | 49.16 ± 1.53% | 64.03 ± 1.66% |
| Na | 0.88 ± 0.34% | 1.09 ± 0.40% | 0.33 ± 0.06% | 0.38 ± 0.06% | 0.65 ± 0.13% |
| Mg | 0.12 ± 0.01% | 0.07 ± 0.08% | 0.35 ± 0.05% | 0.16 ± 0.03% | 1.06 ± 0.11% |
| P | 3.25 ± 0.17% | 3.94 ± 1.23% | 10.22 ± 0.9% | 4.61 ± 0.64% | 8.89 ± 0.61% |
| Cl | 0.335 ± 0.25% | 1.24 ± 0.99% | - | - | - |
| Ca | 4.11 ± 0.46% | 9.2 ± 3.4% | 15.85 ± 1.12% | 7.08 ± 2.28% | 12.56 ± 1.45% |
| Al | - | 0.03 ± 0.055% | - | - | - |
| Ca/P | 1.26 ± 0.13 | 2.34 ± 1.29 | 1.55 ± 0.03 | 1.54 ± 0.36 | 1.41 ± 0.06 |
XRD was utilized to determine the crystalline structure of each of the materials analyzed in this study. The data were characterized by the X-ray intensity (cps) as a function of the diffraction angles (2 theta, θ). All samples that were tested gave a primary compound, which was Hydroxyapatite (HA, Ca10(PO4)6(OH)2). Since the value of 2 theta was constant (which implies the peaks of hydroxyapatite), data from the JCPDS database were analyzed and used to identify the compound. The Hexagonal System was observed in all samples since the axis system was a = b ≠ c and the angle system was α = β, γ = 120° (Table 3). Moreover, through Scherrer’s equation, the crystalline size was calculated by computing the FWHM values. It was demonstrated that Cerabone had the largest crystallite size, followed by Bio-oss, torus mandibularis, torus palatinus, and Oragraft (6.24 nm) (Table 3). Moreover, Cerabone had the narrowest peak, followed by Bio-oss, torus mandibularis, torus palatinus, and Oragraft (Figs. 3a–e).
Table 3.
| Sample Name | Compound | Formula | System | Obs. max 2-theta | FWHM | Crystallite Size |
|---|---|---|---|---|---|---|
| Tori palatinus | Hydroxyapatite | Ca10(PO4)6(OH)2 | Hexagonal | 31.92 | 1.369 | 6.31 nm |
| Tori mandibularis | Hydroxyapatite | Ca10(PO4)6(OH)2 | Hexagonal | 31.83 | 1.164 | 7.42 nm |
| Bio-oss | Hydroxyapatite | Ca10(PO4)6(OH)2 | Hexagonal | 31.88 | 0.8234 | 10.84 nm |
| Oragraft | Hydroxyapatite | Ca10(PO4)6(OH)2 | Hexagonal | 31.95 | 1.383 | 6.24 nm |
| Cerabone | Hydroxyapatite | Ca10(PO4)6(OH)2 | Hexagonal | 31.78 | 0.1727 | 49.97 nm |

3.2. Calcium Dissociation Test
Unstimulated Ca released from the grafting samples was measured in triplicate on the first, third, fifth, and seventh days. On the first day, Ca released from torus palatinus had the highest amount at 4.25 mg/L, while that from the other materials was as follows: torus mandibularis, 3.27 mg/L; Bio-oss, 3.11 mg/L; and Cerabone, 2.52 mg/L. On the third and fifth days, we observed that the highest amount of Ca release was from Bio-oss (3.46 mg/L) compared with that of the other grafts, as follows: torus palatinus, 3.29 mg/L; Cerabone, 2.53 mg/L; and torus mandibularis, 2.05 mg/L. Moreover, release of Ca into the supernatant of all types of bone grafts was still observed at high levels after seven days. Statistically significant differences are shown among all samples from each day in Fig. (4).
3.3. Microbial Analysis
The bone samples collected from the tori were initially cultured in a thioglycollate broth, with the weight of the bone samples ranging from 0.01 to 0.004 mg. The outcomes of microbial growth in thioglycollate media for all bone samples presented with a positive turbidity test within 24 h of incubation (Table 4). Different levels of turbidity were observed via visual examination in all samples, which indicated microbial contamination.

| Specimen | Turbidity test (24 h) | Aerobic growth (2 d) | Anaerobic growth (5 d) | Bone weight (mg) |
|---|---|---|---|---|
| 1 | + | + | + | 0.02 |
| 2 | + | + | + | 0.02 |
| 3 | + | + | + | 0.01 |
| 4 | + | + | + | 0.02 |
| 5 | + | + | + | 0.02 |
| 6 | + | + | + | 0.03 |
| 7 | + | + | + | 0.01 |
| 8 | + | + | + | 0.02 |
| 9 | + | + | + | 0.04 |
| 10 | + | - | + | 0.03 |
To verify the results of the turbidity tests, all positive cultures were subcultured in enriched BA and incubated under both aerobic and anaerobic conditions. Growth under aerobic conditions was observed in nine samples, and growth under anaerobic conditions was observed in all samples (Table 4). Colony morphology and gram staining were also assessed (Fig. 5). All samples showed predominantly Gram-positive cocci.
4. DISCUSSION
The majority of previous studies investigating tori have primarily focused on either their prevalence or etiology. Although there have been numerous case studies regarding the usage of tori as a bone grafting material, there have not been any detailed studies regarding their properties, especially in terms of their inorganic components. To further understand the characteristics of tori, our present study investigated their inorganic properties via physical and chemical analyses.
In the present study, SEM analysis showed clear differences between tori and bone graft substitutes. For example, an irregular and rough surface structure was found for tori, while bone graft substitutes presented a smooth but dry pattern. Furthermore, there was an absence of lacunae (Haversian canals) or dilated blood vessels in tori samples, which are commonly seen in normal bone tissue. In contrast, Kün-Darbois et al. observed the presence of Harversian canals in 17 out of 18 tori samples. Furthermore, 16 out of 18 samples revealed a characteristic of a lamellar bone, while 2 out of 18 samples presented a mixed woven bone [13]. The absence of Haversian systems or dilated blood vessels in our samples may be explained by a different size of tori sample since the retrieval process of the tori samples in our present study was performed using a bone collector, such that the bone samples were grounded to a particulate.
In our present study, the common elements that were observed from all materials were carbon, oxygen, sodium, magnesium, calcium, and phosphate. The Ca/P ratios of allograft, xenograft, and alloplast samples analyzed from our study were similar to those reported in previous studies [28, 30, 31, 33]. We found that chlorine was observed only in tori samples and may have originated from a contamination of the normal saline solution used for irrigation during surgery. Interestingly, we found aluminum in one torus mandibularis samples, which contributed to a total atomic percentage of 0.03%. Chapperd et al. demonstrated deposition of aluminum in the hydroxyapatite of the bone matrix in some clinical circumstances such as in patients with Coeliac disease (which is caused by a prolonged intake of aluminum-based anti-acids), hemochromatosis, sickle cell anemia, or those who underwent hip/knee replacement surgeries in which metal implants had undergone erosion. It is noteworthy that aluminum is also seen in the bony exostosis of patients with similar circumstances. Although aluminum can be locally identified via EDS and Wavelength-Dispersive X-ray Spectroscopy (WDS) from bone samples, its effects on the biological environment and on bodily function remain unknown [34].
Calcium and phosphate have been widely used for bone regeneration due to their osteoconductive properties. Regulation of osteoblasts and osteoclasts to facilitate bone regeneration is managed by calcium and phosphate via adhesion, proliferation, and bone formation. Cell adhesion affects the adsorption of extracellular-matrix proteins on the surface, as well as the induction of new bone. Calcium and phosphate degradation and ion release are key factors that exhibit many bioactive characteristics. Different types of calcium phosphates have been utilized for different bioactivities (hydroxyapatite, tricalcium phosphate) [28, 33, 35-37]. The release of calcium ions from materials is generally defined by the following factors: surface area per unit volume, fluid convection, acidity, and temperature. In our present study, the steady and constant release of Ca that was seen from both Bio-oss and Cerabone may have been attributed to the above factors. The release of phosphate from Bio-oss and Cerabone was found to be consistent with that of the release of calcium, but the release of phosphate from tori was erratic (data not shown). However, many studies have suggested that phosphate dissociation usually shows a similar pattern to that of calcium release [33, 38]. Therefore, the varying release of phosphate that we observed for tori in our present study remains unknown and may warrant further investigation in future studies.
X-ray diffraction offers an in-depth analysis of the crystallinity and crystal phases of analyzed materials. All samples in the present study had well-defined peaks, which indicated well-crystallized components. The analyzed materials had the most intense diffractions at 2θ at 32°. The size of the crystallite was also computed via Scherrer’s formula; it was observed that Cerabone had the largest crystallite size, while Oragraft had the smallest crystallite size. It was also observed that all samples had a hexagonal crystal class, which serves as a good scaffold for bone formation since the hexagonal crystal class has been reported to be stable in previous studies [31, 39, 40]. The main crystal compound in our present study was hydroxyapatite. This is in contrast to findings from previous studies [31, 41] in which Bio-oss primarily showed silicate hydroxide and Cerabone showed calcium gadolinium oxide phosphate. Although the hexagonal class was seen in our study for HA, it can also have a monocyclic configuration. However, HA takes on the hexagonal crystal class in biological systems and is the most stable inorganic component in mineral tissues, with low solubility in physiological environments [38-40]. A previous study on the biocompatibility properties of HA demonstrated that in-vivo bone regeneration was improved in the presence of HA via enhancing the proliferation of stem cells, as well as by increasing the adhesion of osteoblasts [36, 37, 40]. In addition, HA applied clinically does not cause inflammatory responses [41].
One of the disadvantages of autogenous bone grafts is microbial contamination. In the present study, a stringent aspiration protocol was performed with two separate suction machines and a single bone collector in order to minimize the possibility of contamination. However, the results showed positive microbial contamination in all tori samples, which coincides with other reports regarding the presence of microbial growth in all of their samples and graft materials using the same surgical methods [25-27]. Although specific identification of bacterial species was not performed in our present study, various types of colony morphology on enriched BA plates indicated mixed bacterial contamination since the gram staining of colonies from both aerobic and anaerobic cultures showed gram-positive cocci. Moreover, the presence of anaerobic and gram-negative bacteria was reported by the previous studies, it can be concluded that contaminated bacteria were predominantly gram-positive cocci, presumably oral streptococci.
CONCLUSION
In conclusion, our study revealed that tori bone was different from bone graft substitutes in terms of surface structure, crystallinity, and calcium phosphate concentration, but was similar in terms of elemental composition and crystal compounds, which may affect their clinical applications and performances. Despite a stringent aspiration protocol and preoperative rinsing of chlorhexidine, we found that there was still microbial contamination in both samples from tori palatinus and mandibularis post-surgery. As a viable option for bone grafting, tori bone should be considered as a material for bone grafting, which is not only practical but also cost-efficient for patients. Finally, future studies elucidating the biological properties of tori, as well as additional clinical trials, may further promote the clinical use of tori a bone grafting material.
ETHICS APPROVAL AND CONSENT TO PARTICIPATE
Although the present study was laboratory-based, human bone samples were collected. All methods and experimental protocols were approved by the Faculty of Dentistry/Faculty of Pharmacy1 Mahidol University, Institutional Review Board, Thailand. The approval protocol number was COE.No.MU-DT/PY-IRB 2018/061.2012).
HUMAN AND ANIMAL RIGHTS
No animals were used in this research. All human research procedures followed were in accordance with the ethical standards of International Guidelines for Human Research Protection such as Declaration of Helsinki, the Belmont Report, CIOMS Guidelines and the International Conference on Harmonization in Good Clinical Practice (ICH-GCP).
CONSENT FOR PUBLICATION
Written informed consent was obtained from each participant.
AVAILIBILITY OF DATA AND MATERIALS
The data that support the findings of this study are available from the corresponding author, [D.S], upon reasonable request.
FUNDING
This study was supported by Mahidol University and Master of Science program in Oral and Maxillofacial Surgery, Faculty of Dentistry, Mahidol University, Thailand.
CONFLICT OF INTEREST
All authors declare that they have no conflicts of interest to report regarding the present study.
ACKNOWLEDGEMENTS
The authors acknowledge Nisanat Lakkhanachatpan for her technical assistance, as well as all staff members in the Department of Oral Microbiology, Department of Oral and Maxillofacial Surgery, and Department of Oral Biology, Faculty of Dentistry at Mahidol University.


